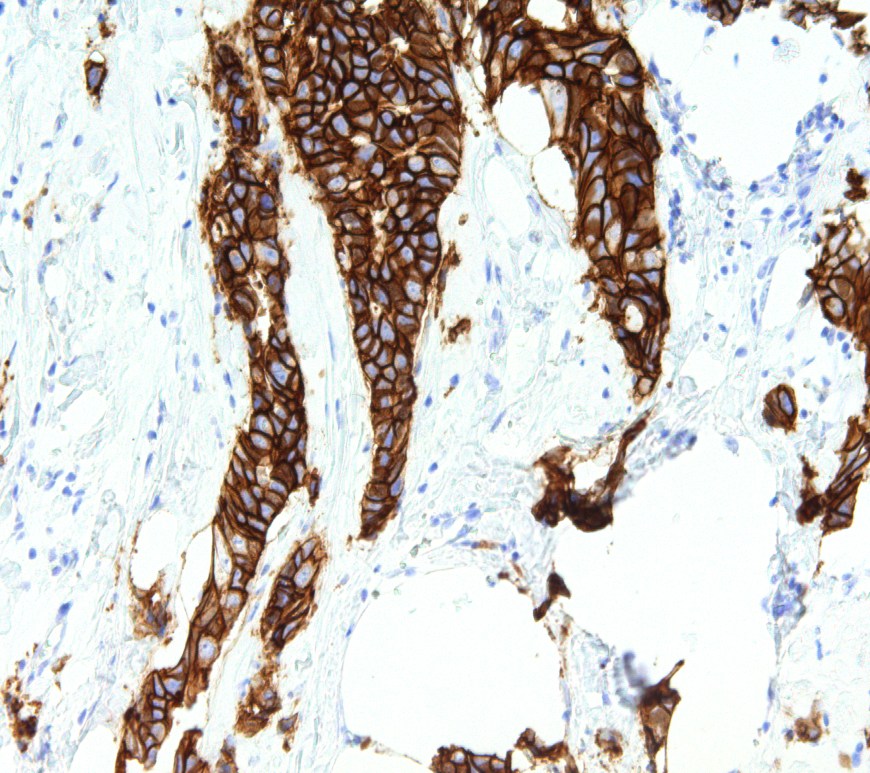

Exploring the Therapeutic Potential of Melatonin in Endometriosis Management
Author: Kimberly Johnston ’26 Endometriosis is defined by the growth of endometrial tissue outside the uterus where it does not belong. It occurs in about 10% of women of reproductive age and leads to chronic pelvic pain and infertility. Despite the prevalence of this disease, its cause remains unknown. While there is no known cure to endometriosis, there are methods of symptom management, including hormone … Continue reading Exploring the Therapeutic Potential of Melatonin in Endometriosis Management